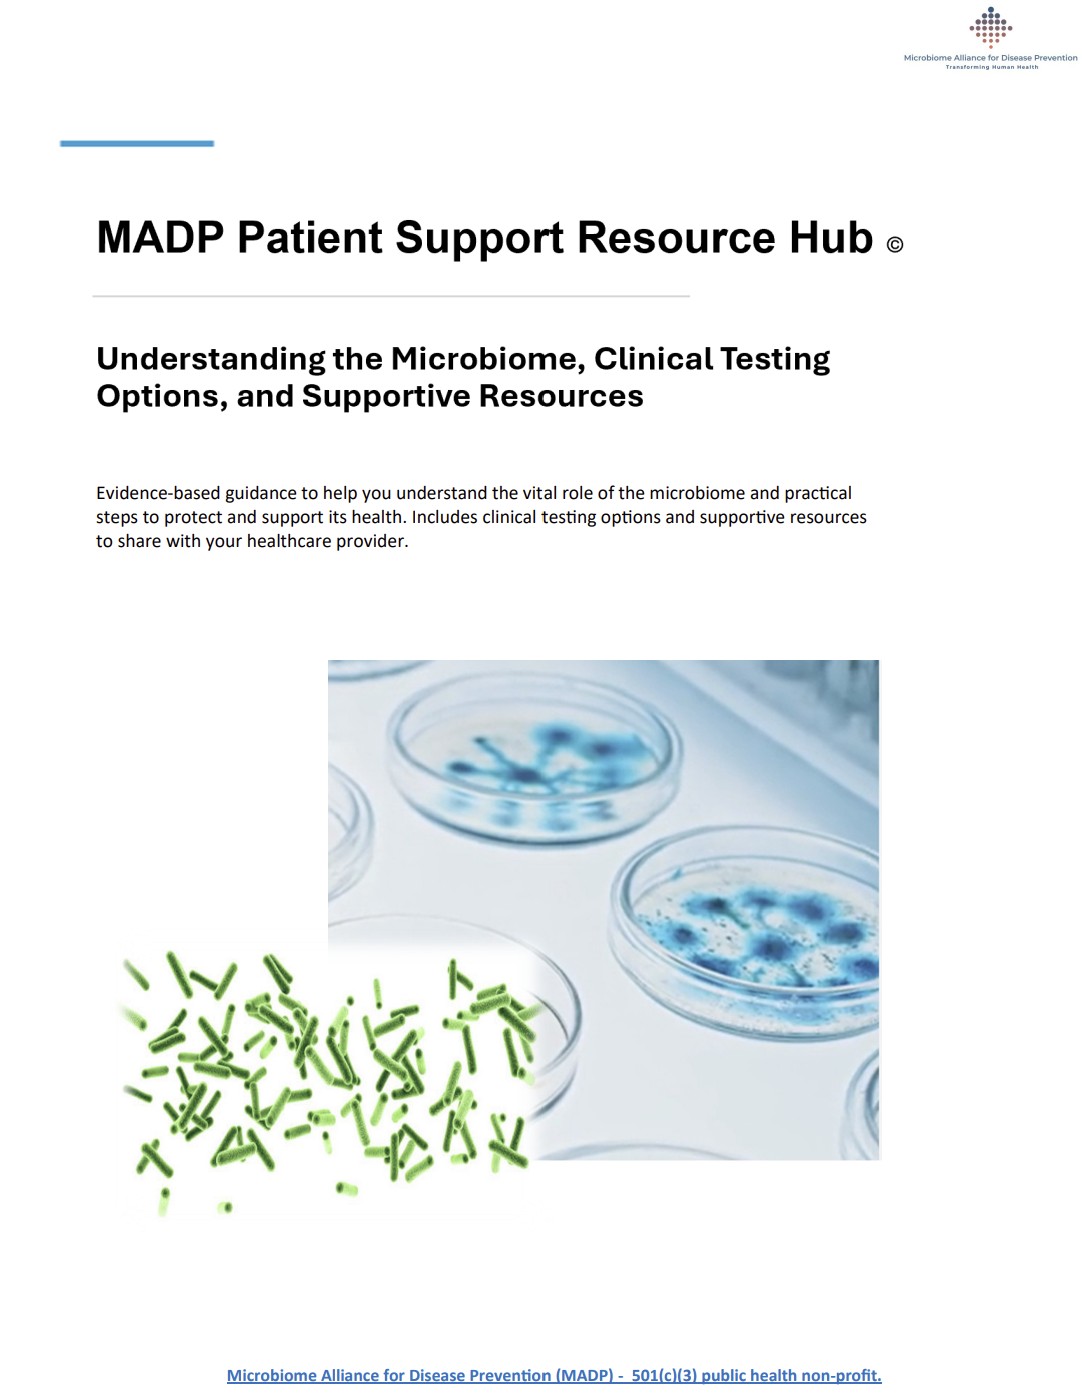

One of the most exciting frontiers in modern medicine is the human microbiome – the trillions of microorganisms that live in and on our bodies and play an essential role in maintaining health.
Scientific discoveries over the past decade have transformed our understanding of the microbiome. Once viewed primarily as gastrointestinal, the gut microbiome is now recognized as a complex biological system that influences metabolism, immune function, inflammation, medication response, and even outcomes in cancer therapy.
These insights are helping guide the next era of precision medicine, where prevention and care can be informed by each person’s unique biological profile, including their microbiome. Originally founded as the Microbiome Alliance for Disease Prevention, MADP recognizes the importance of the microbiome as a cornerstone of human health.
Researchers at leading institutions — including Mayo Clinic, Stanford University, and Memorial Sloan Kettering Cancer Center — continue to advance our understanding of how the microbiome influences disease risk, early detection, and treatment response.
MADP remains at the forefront of microbiome-focused precision medicine by translating emerging science into practical prevention and clinical care — helping ensure that new discoveries, medical-grade diagnostic testing, and evidence-based therapeutic applications, including fecal microbiota transplantation (FMT) for life-threatening C. difficile infections — reach patients sooner and are responsibly integrated into everyday clinical practice.
As research continues to advance, the microbiome is becoming an important area of focus in efforts to support more personalized and preventive approaches to care.
Integrating the microbiome into the diagnosis and management of disease can provide valuable evidence to better understand disease progression and inform treatment decisions – particularly in inflammatory, immune, and systemic conditions.
~ American Journal of Public Health

One of the most established clinical applications of microbiome science is fecal microbiota transplantation (FMT). In hospital settings, FMT is used to treat severe or recurrent Clostridioides difficile (C. difficile) infections — serious infections that can occur when antibiotics disrupt the normal balance of beneficial gut bacteria.
FMT works by transferring carefully screened stool from healthy donors, which is processed and stored through specialized clinical donor programs. The prepared stool transplant is then delivered to the patient’s gastrointestinal tract — often through colonoscopy or other clinically supervised methods — to help restore a healthy microbial balance.
By reintroducing beneficial microbes, FMT can rebuild microbial diversity, suppress harmful bacteria, and restore normal gut function. For patients with recurrent C. difficile infections who have not responded to standard therapies, this treatment can be life-saving.
Clinical studies have shown success rates exceeding 85–90% for recurrent C. difficile infections, and the therapy is supported in treatment guidelines from major medical organizations, including the American College of Gastroenterology (ACG) and the Infectious Diseases Society of America (IDSA).
Researchers continue to study the potential role of microbiome-based therapies in other conditions — including inflammatory bowel disease (IBD), irritable bowel syndrome (IBS), metabolic disorders, and immune-related conditions — though these applications remain under active investigation.
MADP Microbiome Insight
The first two years of life represent a critical window for the development of the human microbiome and immune system. During this period, trillions of beneficial microorganisms begin to colonize the infant’s body – particularly in the gastrointestinal tract – forming a complex microbial ecosystem that plays an essential role in guiding immune development.
Approximately 70% of the body’s immune cells are located in and around the gastrointestinal tract, where they interact continuously with the gut microbiome. These interactions help “train” the immune system – supporting its ability to distinguish between beneficial microbes, harmless environmental exposures, or potential pathogens. This early immune education helps the body learn the difference between “friend and foe.”
Several factors influence this process, including:
Mode of delivery (vaginal birth or cesarean section).
Breastfeeding and early nutrition.
Environmental exposures (caregivers, siblings, pets, natural environments).
Introduction of diverse foods during infancy.
Responsible and appropriate use of antibiotics.
Emerging research – often described as the “biodiversity” or “microbial exposure” hypothesis – suggests that reduced exposure to diverse environmental microbes early in life may contribute to the increasing prevalence of food allergies and other inflammatory conditions.
Nutrition also plays a central role. Breast milk provides beneficial bacteria and human milk oligosaccharides (HMOs), which nourish healthy gut microbes and support immune maturation. As infants transition to solid foods, fiber-rich fruits, vegetables, and diverse whole foods further support microbial diversity.
Supporting healthy microbiome development early in life – through balanced nutrition, safe environmental exposure, and proper medical care – helps lay the foundation for long-term immune health.
The Microbiome and Cancer Research
The microbiome is also becoming an important area of research in cancer science. Studies suggest that microorganisms within the body may influence the tumor microenvironment — the complex ecosystem surrounding cancer cells that can affect tumor growth and response to treatment.
Researchers at major cancer centers, including the Mayo Clinic Center for Individualized Medicine – Microbiomics Program, are investigating how microbiome patterns may help improve understanding of cancer development and treatment outcomes. In one study, investigators identified a distinct microbiome associated with ovarian cancer, raising the possibility that microbiome research could one day contribute to earlier detection and more personalized treatment strategies.
While this field is still evolving, microbiome research represents an exciting opportunity to expand our understanding of cancer biology and support the development of more precise prevention and treatment approaches in the future.
“A big topic that we’re seeing in medicine these days, is our interaction with our body and the microorganisms that live on or in us. Different microbiome patterns in patients can be associated with certain diseases.
For example, we now know there is an association with a microbial imbalance in the colon that contributes to colon cancer, most likely via an overabundance of a bacterium known as Fusobacterium.”
Jordon Laser, MD – 2023 AMA’s What Doctors Wish Patients Knew™

To help patients and families better understand the growing role of the microbiome in health, MADP has developed a comprehensive Patient Support Guide: Understanding the Microbiome, available through the MADP Patient Support Hub.
This educational resource was created to provide patients with reliable information, helping individuals make informed decisions about their microbiome health in partnership with their healthcare providers.
The MADP Patient Support Guide includes:
It is important to understand that microbiome testing results may vary across different laboratory methods. Findings reported in the scientific literature may not always align exactly with results from individual laboratory testing due to differences in testing approaches, reference ranges, and interpretation.
For individuals interested in medical-grade microbiome testing, Genova Diagnostics is a well-established provider of advanced medical-grade diagnostic testing, with more than 40 years of experience supporting clinicians and patients. Since 1986, Genova Diagnostics has offered specialized laboratory services and maintains a physician-led team dedicated to supporting healthcare providers.
If you are exploring gut health testing, we encourage you to review the Genova Diagnostics Patient Brochure [HERE] and share the Physician Brochure [HERE] with your healthcare provider to help guide discussions about whether testing may be appropriate for you.
As with all laboratory testing, it is important to consult with a qualified healthcare professional to determine appropriate next steps and whether any interventions are right for you.
Healthcare providers seeking additional clinical information related to microbiome testing or guidance in supporting their patients are welcome to contact MADP directly at info@microbiomeDP.org. Our team can connect clinicians directly with the Genova Diagnostics medical team for further support.
We invite healthcare providers to review the comprehensive Genova Diagnostics Clinical Stool Testing Support Guide [HERE] for detailed clinical insights to help determine appropriate testing and interpretation for patients.
Evidence-based guidance to help you understand the important role of the microbiome and practical steps to protect and support its health. Includes clinical testing options and supportive resources to share with your healthcare provider.
Every individual’s health history and medical needs are different, decisions about testing or treatment should always be made in partnership with a qualified healthcare professional.
~ MADP Alliance for Disease Prevention
MADP’s Wait—Don’t Flush! Look First™ is a three-tiered national public health initiative created in response to the rising incidence of early-onset colorectal cancer (EOCRC) among young adults under age 45 — including individuals in their late teens, 20s, 30s, and 40s.
Colorectal cancer is now one of the leading causes of cancer death among adults under age 50 in the United States, and incidence in younger populations has been rising steadily for more than two decades. Many young adults are diagnosed at later stages because early symptoms — such as rectal bleeding, persistent changes in bowel habits, abdominal pain, iron-deficiency anemia, or unexplained weight loss— are often overlooked or attributed to less serious conditions.
Through education, awareness, and patient advocacy, this three-tiered initiative encourages individuals to recognize warning signs sooner and seek timely medical evaluation — when early detection can save lives.


MADP Wait—Don’t Flush! Look First™
A National Public Health Initiative
MADP Three-Tiered Public Health Campaign
to Prevent Early-Onset Colorectal Cancer
Join Us In This Important Call To Action.
Earlier recognition matters.
Earlier action matters.
And earlier detection saves lives.